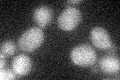
YJL133W
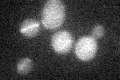
YJL133W
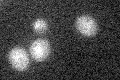
YJL133W

View description
Iron transporter that mediates Fe2+ transport across the inner mitochondrial membrane; mitochondrial carrier family member, similar to and functionally redundant with Mrs4p; active under low-iron conditions; may transport other cations
Localization:
Intensity:
Fold change:
Significance:
-
C’ GFP library in SD
below threshold16.16 -
N' NOP1pr-GFP in SD

N/A0 -
N' TEF2pr-mCherry in SD

N/A0 -
N' NATIVEpr-GFP in SD

N/A0 -
N' TEF2pr-VC and Cyto-VN in SD

N/A0 -
C’ GFP library in SD+DTT

cytosol14.360.88No -
C’ GFP library in SD+H2O2
cytosol14.590.9No -
C’ GFP library in Starvation Media
cytosol14.920.92No -
C’ GFP library on the background of Pup2-DaMP

below threshold -
C’ GFP library on the background of CCT mutant

below threshold15.73370.973267No
